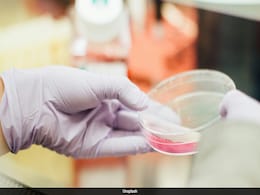
Vietnamese Father Discovers Daughter Was Swapped At Birth Through DNA Test Vietnamese Father Discovers Daughter Was Swapped At Birth Through DNA Test

Hospital Error
-
{
- All
- News
- Videos
'Hospital Error' - 1 News Result(s)
-

Vietnamese Father Discovers Daughter Was Swapped At Birth Through DNA Test
- Saturday November 9, 2024
- Offbeat | Edited by Nikhil Pandey
This revelation led to a journey uncovering a hospital mix-up, with the truth emerging when the daughter met another girl born on the same date at a new school.
-
 www.ndtv.com
www.ndtv.com
'Hospital Error' - 1 News Result(s)
-

Vietnamese Father Discovers Daughter Was Swapped At Birth Through DNA Test
- Saturday November 9, 2024
- Offbeat | Edited by Nikhil Pandey
This revelation led to a journey uncovering a hospital mix-up, with the truth emerging when the daughter met another girl born on the same date at a new school.
-
 www.ndtv.com
www.ndtv.com